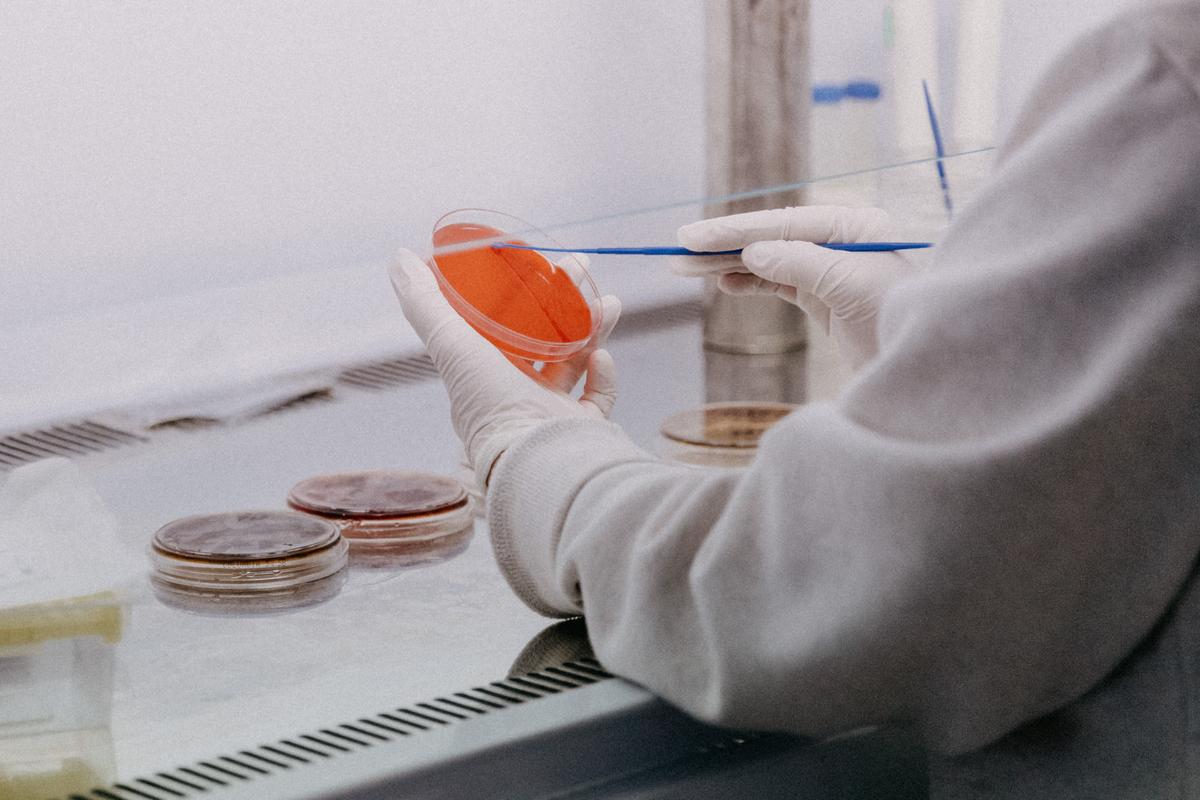
Covid 19 variant britannique Algerie

Dans la soirée du jeudi 25 février, l'Institut Pasteur d'Alger a confirmé dans un communiqué avoir détecté la présence du variant britannique du Coronavirus chez deux personnes.
L'Institut Pasteur précise dans son communiqué que "Ces deux souches mutantes ont été détectées chez un membre du personnel de l'EHS de Psychiatrie de Chéraga (en isolement actuellement) et chez un immigré venu de France pour l'enterrement de son père".
A ce sujet, le Ministre de la Santé algérien, Abderrahmane Benbouzid, s'est voulu rassurant lors de la dernière conférence de presse en indiquant que les experts sont à "l'affût de cette mutation" et sont "vigilants".
Quant à la suspension des vols à destination de l'Algérie durant tout le mois de mars, aucun communiqué officiel n'a confirmé cette information véhiculée à ce jour par des médias locaux.
Sur le même sujet







